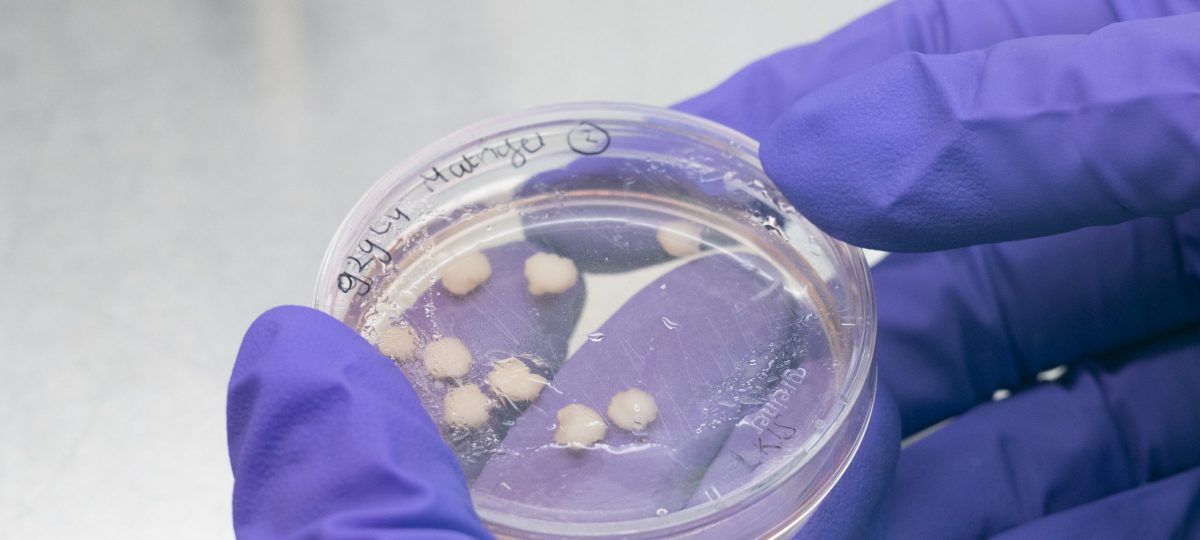

De Hersenstichting draagt met € 75.000 bij aan onderzoek van Amsterdam UMC en UMC Utrecht. Het onderzoek staat onder leiding van Elly Hol en Elga de Vries. Doel van het onderzoek is om in het laboratorium een werkend model van de bloed-hersenbarrière na te maken en die te koppelen aan nagemaakte mini-hersenen. Als dat lukt, maakt dit veel nieuwe onderzoeken naar medicijnen voor hersenaandoeningen mogelijk. Dat geeft veel mensen met een hersenaandoening hoop op het vertragen, stoppen of zelfs genezen van hun aandoening.
Liever de video bekijken met minder prikkels? Bekijk dan hier de animatie zonder muziek.
Wil je liever over het onderzoek lezen? Lees dan hieronder verder.
De hersenen worden soms te goed beschermd
Dankzij wetenschappelijk onderzoek weten we al enorm veel over de hersenen. En dankzij al dat onderzoek zijn er behandelingen voor allerlei hersenaandoeningen ontwikkeld. Maar de meeste hersenaandoeningen zijn nu nog niet of nauwelijks te behandelen.
Een groot probleem is het vinden van medicijnen die de hersenen bereiken. Dat komt door de bloed-hersenbarrière, een laagje van speciale cellen dat in de bloedvaten in de hersenen zit. Het is een soort grens tussen het bloed en de hersenen: goede stoffen mogen erdoor, slechte niet. De bloed-hersenbarrière beschermt de hersenen dus tegen schadelijke stoffen, zoals bacteriën of giftige stoffen.
Het nadeel van de bloed-hersenbarrière is dat deze ook veel medicijnen tegenhoudt. Onderzoekers willen manieren vinden om medicijnen toch langs die barrière te helpen. Maar dat is erg lastig. Het testen bij mensen kan bijvoorbeeld erg gevaarlijk zijn. En onderzoek bij dieren heeft onder andere als nadeel dat die hersenen niet genoeg op die van mensen lijken.
Onderzoek met nagemaakte hersenen
Een mogelijke oplossing is het testen van medicijnen op een soort nagemaakte mini-hersenen. Onderzoekers worden steeds beter in het namaken van menselijke cellen in het laboratorium. Op die manier kunnen ze goed onderzoek doen, zonder mensen of dieren in gevaar te brengen.
CONNECT is een samenwerking van verschillende onderzoekers en bedrijven die werken aan het maken van deze mini-hersenen. Samen met Stichting Proefdiervrij draagt de Hersenstichting geld bij aan dit consortium, dat verder wordt betaald door NWO, Health Holland en de Samenwerkende GezondheidsFondsen (SGF).
De onderzoekers willen in het laboratorium een werkende bloed-hersenbarrière namaken. Die willen ze vervolgens koppelen aan nagemaakte mini-hersenen. Als dat lukt, kan er beter onderzoek worden gedaan naar manieren om medicijnen voorbij de bloed-hersenbarrière te brengen. En kan het effect van verschillende stoffen op de menselijke hersenen getest worden. Zo worden de hersenen beter bereikbaar voor het behandelen van een hersenaandoening.
Waarom steunt de Hersenstichting dit onderzoek?
De Hersenstichting wil dat de hersenen beter bereikbaar worden voor de behandeling van hersenaandoeningen. Daardoor kunnen we in de toekomst ernstige hersenaandoeningen zoals dementie, hersentumoren, depressie en beroertes vertragen, stoppen en mogelijk zelfs genezen. Dat biedt nieuwe mogelijkheden en hoop voor de 4 miljoen Nederlanders met een hersenaandoening. Daarom steunt de Hersenstichting dit onderzoek met € 75.000.
Hoe pakken ze dit aan?
Om de bloed-hersenbarrière te kunnen koppelen aan de mini-hersenen zijn er verschillende onderdelen nodig. Daar wordt in dit onderzoek aan gewerkt.
Speciale gel: hier groeien de cellen in waarmee je hersenen na kunt bouwen. Hiervoor worden vaak dierlijke stoffen gebruikt. De onderzoekers willen deze gel maken zonder dierlijke stoffen.
Speciaal bakje: hierin worden de hersenen nagemaakt. In dit bakje worden bloedvaten gemaakt, die worden verbonden met de mini-hersenen.
Eerst worden de bloedvaten en de hersencellen apart gekweekt. Als dat lukt willen de onderzoekers ze samen kweken en zo een bloed-hersenbarrière bouwen, en deze koppelen aan de mini-hersenen. Daarna kan getest worden of die ook stoffen kan tegenhouden en doorlaten.
Welke resultaten verwachten de onderzoekers?
De onderzoekers verwachten de bloed-hersenbarrière na te kunnen maken in het laboratorium en te kunnen koppelen aan nagemaakte mini-hersenen.
Hoe ver is het onderzoek?
Het onderzoek is gestart in het najaar van 2021. De onderzoekers verwachten dat zij eind 2025 de resultaten kunnen delen.
Wat is de volgende stap?
Als het lukt om de bloed-hersenbarrière na te maken en te koppelen aan de nagemaakte mini-hersenen, kunnen andere onderzoekers daarmee beter onderzoek doen. Ze kunnen zo op zoek naar behandelingen die door de bloed-hersenbarrière nu nog niet werken.

Dit onderzoek wordt gefinancierd door de Samenwerkende GezondheidsFondsen (SGF), NWO domein TTW en ZonMw als onderdeel van hun strategische onderzoeksprogramma: humane meetmodellen. Dit samenwerkingsproject is medegefinancierd door PPS-toeslag die beschikbaar is gesteld door Health~Holland, Top Sector Life Sciences & Health, aan NWO namens SGF om publiek-private samenwerkingen te stimuleren.
Fotocredit: Proefdiervrij, gemaakt door Bas Keijzers.